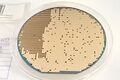
125wafer01 004.jpg

웨이퍼
웨이퍼
- 전자부품
- 규격서
- SAW 웨이퍼
- - 3p
- SAW 웨이퍼
- 웨이퍼 분석 엑셀
- 반지름 특성 분석 엑셀 파일
- 웨이퍼 직경
- 순수 실리콘 웨이퍼 12인치와 6,4,2인치 비교
- 순수 실리콘 웨이퍼 12인치와 6,4,2인치 비교
- 사파이어 웨이퍼, Sapphire wafer
- 실리콘 웨이퍼
- 다이를 경사지게 가공(MEMS)한 예를 분석 샘플에 찾아보니
- 카메라 센서
- 지문 센서
- 가속도, 자이로 센서
- 조도 센서
- MEMS 마이크
- 치수
- flat
- 8, 10, 12인치 웨이퍼는 flat이 있지 않고 notch가 있다.
- 두께
- 5인치:0.5mm, 6인치:0.6mm 이상, 8인치:0.7mm 이상, 12인치:0.75mm 이상
- flat
- 300mm(12인치) 웨이퍼
- 순수 실리콘 웨이퍼에서 다이싱 테스트용
- 플래시 메모리로 추측
- 외관
- 다이
- 외관
- 순수 실리콘 웨이퍼에서 다이싱 테스트용
- 150mm(6인치) 웨이퍼
- 치수
- 직경 150.0+-0.5mm, flat 57.5+-2.5mm, 두께 0.6mm
- 치수
- 125mm(5인치) 웨이퍼
- 치수
- 직경 125.0+-0.5mm, flat 42.5+-2.5mm, 두께 0.5mm
- 실리콘 다이오드 웨이퍼
- 치수
- 100mm(4인치) 웨이퍼
- 웨이퍼 그립 링(wafer grip ring)에 있는, 사용후 남은 불량칩
- 웨이퍼 그립 링(wafer grip ring)에 있는, 사용후 남은 불량칩
- 다이를 경사지게 가공(MEMS)한 예를 분석 샘플에 찾아보니